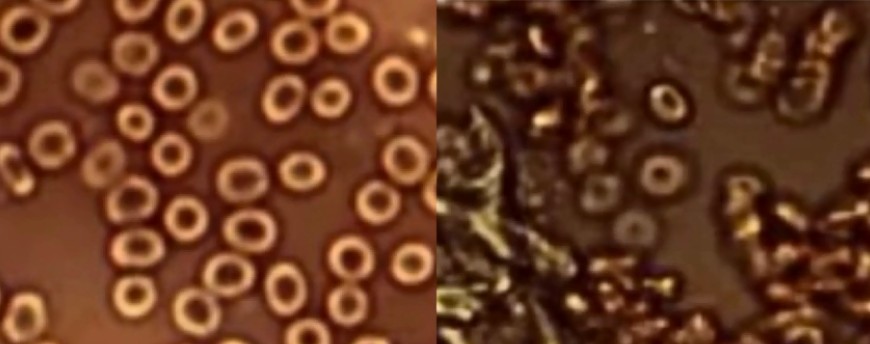

by Dee McLachlan
It feels like we are spiraling into a world devoid of any logic — especially as we, in Melbourne, are locked down for the 5th time. I suspect were are in the “conditioning” phase. I mean what the hell is going on?
Boris Johnson has had COVID, and he’s fully vaccinated, but he still has to isolate himself and walk around with a MASK on when in a hot zone.
And even though children in the UK have a one in 500,000 (or less) risk of dying from Covid, The Telegraph reported, “Covid vaccines [EXPERIMENTAL gene therapy] would be rolled out to children from as early as August…” In 2018 in Australia, . Maybe ALL Australians should have cardioverter-defibrillators implanted into their bodies because 41,800 people died (2018) from heart failure and Cardiovascular disease. I mean how many lives could we save?
So, in this article, I will try to cover more worrying facts:
Vaccines v Variants — VIRAL IMMUNE ESCAPE
Geert Vanden Bossche DMV, PhD, — the independent virologist and vaccine expert, and former employee at GAVI and The Bill & Melinda Gates Foundation — asks this question: “Why does nobody seem to bother about viral immune escape?”

He explains that starting vaccination trials and then mass vaccination programs mid-pandemic is resulting in the virus escaping — morphing — into more virulent strains (variants) when people have, for example, only been half-vaccinated. And now the world is like a grand bioweapons lab — with the global population being used as a “GAIN OF FUNCTION” experiment.
Instead of the normal “natural decline” of a virus, the result is more and more transmittable and virulent variants (that will need further mRNA booster upgrades). He fears we will be in a perpetual spiral of vaccines and stronger variants leading to real pandemics. Maybe that was always the plan/formula:
PLandemic + gain of function via vax = pandemic.
In his urgent letter Vanden Bossche wrote:
“As a dedicated virologist and vaccine expert… The present extremely critical situation forces me to spread this emergency call. As the unprecedented extent of human intervention in the Covid-19- pandemic is now at risk of resulting in a global catastrophe without equal….”
The second problem is whether the mRNA ‘vaccines’ will FOREVER compromise one’s innate immune system? The mRNA injected message gets your body to form specialized immune antibodies (That’s why boosters will be needed for each major variant). There is a real danger these specialized antibodies will OVERSHADOW one’s magical innate immune system. This is a disaster.
Del Bigtree explains Vanden Bossche’s theory further. (Starts 57 min)
And now to the scientist…
Premeditated Plandemic — Dr Astrid Stuckelberger
Dr Stuckelberger is a scientist, researcher, trainer, author in international health and health with a PhD, Privat-Docent at the Faculty of Medicine of the University of Geneva and Lausanne. As a top researcher, WHO/UN and the EU required her expertise for different programs (i.e. IHR, SDH, Innov8, HiaP, ERC, GINA). She has 12 books and approximately 200 scientific articles, policy papers, governmental and UN reports behind her.
Stuckelberger states that this Covid plandemic has been premeditated. And that “the system has to be dismantled and the key players brought to justice.”
And now to the doctor…
Dr Jane Ruby — Blood Smear Abnormalities
Stew Peters Show interviews Dr Jane Ruby again — this time about the blood smears taken from Moderna vaccinated patients by Dr Van Wellberger (not sure of spelling) and viewed under the microscope. The changes in the blood are dramatic and extremely worrying.
(Dr Ruby’s account of catching Covid is on her website.)
Ivermectin — The Conclusion
It is clear the ‘powers that be’ want humanity to be injected with this gene therapy — and quickly too. It was probably clearly understood that the virus would fade naturally — especially if repurposed drugs (like HCA and Ivermectin) were used aggressively. But now we are headed in the opposite direction.
These diagrams from Mexico explain exactly what they did not want. One region in Mexico focused on Ivermectin and the “pandemic” was no more. These diagrams say it all.
We, humanity, have been conned. I am not ready for the Pass-Mask-Q-code future.































This is core– a repeat of post
ttps://teskilatimahsusa.wordpress.com/tag/mk-ultra-project/page/2/
MK ULTRA PROJECT : TAVİSTOCK INSTİTUTE, AGENDA 21, SOCİAL ENGİNEERİNG & GLOBAL MİND CONTROL
https://exposingpedovore.wordpress.com/2019/12/11/mk-ultra-mindcontrol-levels-of-programming/
I see dead people
The sadist comment I have ever noted.
https://www.youtube.com/watch?v=ZSNyiSetZ8Y
The sadist leading man I have ever noted (almost)
Gday Ned, not sure if your comment was fully intentional, or included a typo, but as a member of the masochistic morons of australia ( membership granted after throwing yourself in front of a tractor.. ) I enjoyed and appreciated it either way.
and yes, thanks fish, i was indeed making reference to that particular scene, but not claiming any psychic ability myself to actually visualise corpses roaming around, I also did intend purposeful ambiguity to equally apply to the long queues of people shown ad nauseam on the sadistic MSM of people lining up for tests and “jabs” <— makes it sound quite cute and harmless when ya say it like that…. just a jab! 🙂
i feel so very saddestic indeed.
I have psychotic ability – here comes the wheelbarrow
https://www.youtube.com/watch?v=8wv8AJ2_EQY
Fair, now that is down right funny! Maybe someone could come up with a T-shirt that has that logo, perhaps with a mask-hole with a syringe in their arm.
Sad actually, the goat took the ride and realised when it was all over…… bloody lot smarter than the stooopids you ‘love’🤣
I see Ned people 😊
Are we still being hoodwinked by scientists, doctors and politicians. The numbers being quoted I would suggest are still figments of imagination being created by the CPR readings.
Dr David Martin explained that there is no such virus a Covid-19, so there cannot be a variant. Are these so-called variants the flu same as the con carried out last year?
We are in winter in Australia and I still have not heard of anyone with the flu. Where are all the deaths? Remember 2020, Victoria supposedly had 820 Covid-19 deaths yet their overall deaths for year were less than each of the previous two years. I have not heard or read of any doctor or scientist explaining how in a world where deaths were lower than the previous year or two, Covid-19 supposedly was the cause of multiple thousands of deaths.
I may not be the most intelligent person on the planet, but neither am I the most stupid.
Remember there is NO Cov19, its another term for the flu! we all have Corona from birth, other wise were not human…Boris Johnson did not have Cov19, it doesn’t exist! to start with.
DR. DERICK KNAUSS (Short 3 min Video)… They put out Influenza A & Influenza B and are calling it COVID-19.
https://www.bitchute.com/video/8NnxnVHnucIE/
Dr Stucklberger certainly knows the game and the plan. Like most people, I have watched hundreds of hours of information on this scam.
Bottom line is we are all screwed, back in 2016 the UN stated that this plan would be implemented, and it would be NOT negotiable once implemented.
Incase you haven’t noticed, the propaganda plan being shoved down our throats daily , has such a strong emphasis on ” Getting the Vaccine ” . WHY we may ask?
Most of the plan’s script’s , allow for Marshall Law to be implemented, and forced Vaccination.
Several countries are already talking about it, and setting up to implement it. This WILL and HAS to happen by the end of 2021.
What can we do ? Truth be told Absolutely NOTHING.
We have allowed this to happen and its here.
The UN has signed member states , which includes those signatories having signed oved ALL sovereignty of that country to the UN. ( Thanks Julia Gilliard )
An inclusion of that singing of rights over includes the countries Judicial rights.
So the UN , has legal rights over Australia , its Government , its Media , and soon IT’S PEOPLE.
Enjoy the rest of our Freedom and or Life ( which ever comes first ).
One point I want to make VERY clear !!!
Dont be fooled into believing ” Get the Jab and we go back to NORMAL ) There is NO going back to life the way it was.
My advice , look into your salvation with God.
Six new mega-prisons in the UK, at least one with crematorium attached. So flu / virus or whatever is enhanced by injections, Boris freedom day to boost “new variants”, everybody locked down twice as hard and non-compliant to mega prison. Makes sense to me.
Anyone striving for biological accuracy need not worry, it is and always was, just a story.
In sharing this, please see disclaimer below and quoted passage following.
• Dr Vernon Coleman – Why and How They Plan To Kill Seven Billion
https://www.bitchute.com/video/0ISEresMOIg0/
What a shame Vernon keeps alluding to the false baseline of ‘nazi’ atrocities, which is fake history and utter projection. Here is some relevant material for context …
• “The Forsaken: An American Tragedy in Stalin’s Russia” by Tim Tzouliadis
• “Execution by Hunger: The Hidden Holocaust” by Dolot Miron
and a reading …
• Dr. William Luther Pierce — #59 The Genocide At Vinnitsa
https://www.bitchute.com/video/yulaOvTVpUm1/
Text here:
http://freepdf.info/index.php?post/Pierce-William-Luther-The-genocide-at-Vinnitsa
(remember, this is quite separate to, and over and above the Katyn massacre of Poles.)
So I can’t let this go without fulfilling my earlier commitment to quote from Tzouliadis … note plenty of names, dates and footnotes:
Pp 101-104, Chapter 9 “Spetzrabota” [Special Work]
“Through the course of 1937 and 1938, Americans such as Victor Herman began to disappear, one after another. Many of the arrested were shot not long afterward, often with their fathers, who had brought them to the USSR. After their denunciation, the baseball players from Boston, Arthur Abolin and his younger brother, Carl, were both arrested and executed with their father, James Abolin, in 1938. Their mother died later, in a concentration camp. Only their younger sister, Lucy Abolin—the precocious drama student of the Anglo-American school—was left untouched.[footnote source 30] Other records emerged that revealed how certain victims were forced to testify against their family members in so-called “confrontation interrogations.” In March 1938, a twenty-five-year-old New Yorker named Victor Tyskewicz-Voskov confessed that his mother had been recruited into “espionage in favor of Germany.” Under extreme duress, Tyskewicz-Voskov denounced his mother to his interrogator as a “Trotskyist, inclined antagonistically against the Soviet power.” The NKVD officers then placed his forty-three-year-old mother in the same interrogation room while her son repeated his denunciation in front of her. His mother bravely confessed her own guilt while steadfastly refusing to implicate her son. They were both executed on June 7, 1938.[ footnote source 31]
Because of the length, I will split this up and hope it passes the minotaur …
Continuing quoted passage from Tzouliadis:
“In the killing fields of Butovo, twenty-seven kilometers south of Moscow, the depressions in the ground later revealed themselves in aerial photography. The mass graves ran for up to half a kilometer at a time. Nor was there anything particularly unique about Butovo. Within the Soviet Union such “zones” were differentiated only by their location. Orders sent from Moscow were applied uniformly throughout the USSR, from the Polish border across one sixth of the surface of the earth to the Pacific Ocean. If the NKVD were instructed that 250,000 people should fill one of the eight mass graves in Byelorussia, then a similar ratio was applied to every other Soviet republic, and every regional district of Russia, too, including the Moscow region itself. At Butovo, exactly the same procedure was followed by the NKVD brigades as elsewhere.[footnote source 32]
In the 1990s, a Russian society for the rehabilitation of Stalin’s victims located within the files of KGB pensioners a “Comrade S.,” the first komendant of an NKVD execution squad who was willing to be interviewed for the historical record. Comrade S. happily discussed his spetzrabota— the so-called special work—which he had performed with his team of a dozen executioners during the Yezhovchina, the days of Yezhov. Comrade S. remembered how his unit had waited in a stone house on the edge of the killing fields while their prisoners’ files were checked. How they led their victims to the edge of the pit and held the standard-issue Nagan pistol to the back of their heads. How they pulled the trigger and watched the bodies crumple and fall into the hole in the earth. And then how they repeated the process over and again until, like every other Soviet worker, they had met their quota for the night’s work. At the end of their shift, Comrade S. and the dozen members of his squad would retire to their stone headquarters exhausted, to drink the liters of vodka specially allocated for the job at hand. Obviously their masters understood the traumatic effect the spetzrabota had on the minds of the executioners. The vodka salved their consciences as the dawn rose over Moscow, and a new day began for the city’s fear-filled inhabitants.; footnote source 33]
In the mornings at Butovo, the executioners heard the sound of the bulldozers covering over the mass graves, and the fresh graves being hollowed ready for the next night’s work. In their stone house they washed their hands and faces, removing the inevitable back-spray of blood, and doused themselves in cheap eau de cologne, once again provided by their masters, who seemed to have thought of everything and who understood that the smell of death clings to those who administer it. Although they were allocated leather aprons and gloves and hats to protect their uniforms from the spattered gore of blood and skull and brain, the men found it was impossible to stay clean.[footnote source 34]
Judging from the undisturbed recollections of Comrade S., the NKVD guards remained convinced they were not murderers but righteous executioners sanctioned by their state. With prolonged ideological training, their moral sense became disguised and distorted by euphemism. The brigade was enforcing the “supreme penalty for social defence,” or administering the “nine-gram ration.” Words such as liquidation or repression inadequately concealed the simple act of murder. While numbed by the repetitiveness of their “special work”, the executioners became as passionless as slaughtermen, too busy for introspection. Their spetzrabota did not end for many years; it kept arriving until it was hardly special any longer, just monotonous in its routine. [footnote source 35] There was, however, one unexpected consequence to their lives. Their work made them wealthy. Each NKVD executioner was paid special ruble bonuses for killing people in “the zones,” so much in fact that their increased salaries excited the envy of their NKVD colleagues not selected for this work. And the ruble bonuses mounted up as, night after night, the pits were filled and new ones were dug again the next morning. [footnote source 36]
In the fields of Butovo, apple trees were planted over the dead. In Depository No. 7, at the Lubyanka, the NKVD entered their names into four hundred bound volumes. Each name was marked with a red pencil and the note “sentence carried out.” From these books, researchers later calculated that 85 percent of the dead were noncommunists, ordinary people who mostly came from the Russian peasantry. Given the scale of the genocide, the fate of the Americans was scarcely a matter of significance. The statistical evidence had no regard for the captain of the Moscow Foreign Workers’ baseball team, Arnold Preedin, or his brother, Walter Preedin, from Boston, Massachusetts, who lay buried in an apple orchard twenty-seven kilometers south of Moscow. [footnote source 37]”
Julius, based on our population of 24 million. If 40% get “vaccinated, equates to 960,000. According to Dr Charles Hoffe estimate 60% of those will die within 3 years. That figure is 576,000 fellow Australians. The 40% “vaccinated” may be a big under estimation.
The main difference between now and what happened in Russia is the the killed were aware what was happening to them and the today’s killers, doctors, nurses, pharmacists and there assistants will not see the bodies fall into their graves.
This all looks like the World War II. was won by Germany, and we have Dr. Mengele as boss of the WHO, and some other fascist bosses as leaders at the UN, EU, and everywhere. And managing all resources.
Of course you have to have helpers … like all Australian “Chief Health Offices”, most state and federal politicians etc – the “willing executioners”, as it were.
http://freepdf.info/index.php?post/MacDonald-Kevin-Stalin-s-willing-executioners
https://www.henrymakow.com/communism_disguises_illuminati.html
“……….America today can be compared to Russia before the Revolution. According to W. Schulgin, “the brain of the nation was in [Illuminati] Jewish hands and it became business, as usual, to think in Jewish categories…In spite of all the restrictions, the Jews controlled the mind of the Russian people.” (Jones, Culture Wars, p. 42) ……………”
Hello,
All the nastiness has gone on forever and continues. The micro-analysis that certain people go over and over with is very blinkered, I know from personal experience, having been dragged in as an “exhibit”. Any decent scholar should be prepared to consider all possibilities.
Maybe this guy is the missing link you two need to be looking at, between the pharaohs and swissy, he just disappeared (!!!) in Rome about 25BC. The pharaohs would have quite a grudge against the jews for obvious reasons and were always trying to get in with Rome. They may have sneaked around to Venice with all the loot when their empire was finally overrun by Octavius (Augustus).
Separately, the Rotschilds emerged as a result of technological advances, they started multinational banking with carrier pigeons, an innovation, only available to jews et al since usury was banned to Christians and muslims. The reserve banks would have evolved out of loans to warring kings. The banker would be unwise to refuse a loan so he would have required as a condition of any loan a share of the reparations from the loser, (to cover his losses from the loser). Once the Rotschilds had got their certificates or “printed money” accepted they would be on a roll. World’s most successful family enterprise.
Is it at all possible in your minds that Rotschild and Pharaohs / Swissy are actually business competitors. Don’t forget the BIS, WEF, “Octagon” etc are all in Switzerland, not London.
https://en.wikipedia.org/wiki/Alexander_Helios
( Hopefully the Democrats don’t get to this page before the reader ).
Like I intimated re the previous post, Jew phobia is just symptomatic of the belief that humanity can be cleaned up from within and a commensurate unpreparedness re the coming Judgement, a process that, by all accounts, has already started to gather momentum.
A little knowledge is always a dangerous thing
In their haste to get these toxins into every body, including children who do not get sickened by this supposed virus, they have exposed themselves as having no scientific data to support this effort and no humanitarian concern for the injuries and deaths they have already caused. Whatever happened to “First do no harm.” A vast number of doctors have been shown to be either utterly blind or completely unethical.
Attorney Files Federal Lawsuit Against CDC Based on “Sworn Declaration” from Whistleblower Claiming 45,000 Deaths Have Been Filed with VAERS – All Within 3 Days of COVID-19 Vaccinations
https://healthimpactnews.com/2021/attorney-files-federal-lawsuit-against-cdc-based-on-sworn-declaration-from-whistleblower-claiming-45000-deaths-have-been-filed-with-vaers-all-within-3-days-of-covid-19-vaccinations/
Propaganda is targeted. To guard against its effects we can only work with what we know for sure. And the only thing about this project we know for sure is that the PCR is not a diagnostic tool – its inventor said so. We can be confident that disease is caused by lifestyle because Pasteur said on his deathbed that germs are BS and that the Terrain of Antoine Bechamp was everything. It’s a sure bet that GPs as we know them will soon be extinct because big tech is so obviously taking over their turf. And traditional remedies for respiratory tract infections of bedrest, chicken soup and lemon juice will be scoffed at as stone age superstitions. Everything else is speculation. That is, except for the conviction of the politicians and bureaucrats. That is frightening. Much scarier than the CGIs we see in the media covered in spikes. And a perfect example of the most dangerous drug known to mankind – ambition.
Covid is the declaration of war by Masonic ‘hoods against all people. Bio-weapons called ‘vaccines’ are made in BSL4 (bio-security weapons labs, level 4 being the most lethal created) factories, there are over sixty globally and Oz has five. To think, people are lining up for this is beyond unbelievable. Crown zionists are joined at the hip and now with their jackboots of 123 million CCP millionaires and billionaires, this wicked triumverate of bloodsuckers are enforcing
the final solution.
By end of August, how many small business and sub-CONtractors, will be left standing with lockstep lockdown. This rapid decimation here didn’t happen overnight, it has been many decades in baking. CCP new jackboots here, just look at the streetscape, new bentleys with p-plates ubiquitous in desired foreshore suburbia. It’s an invasion and we’re not invited, with Josh being the oligarchs rep in Oz, paving the way for arrival of Moshiach in early September, simultaneously with global launch of 5G smart trancehuman 2.0 (beyond stupid).
What’s Moshiach !!!
The spread of Covid 19 is based on 2 factors…
1) How dense the population is.
2) How dense the population is.
Now THAT is funny – T-shirt material [sic]
or bumper bar stickers?
Problem – it’s those who are accepting this rubbish and locking themselves away who are the ones who need to get the message. Anyone out and about likely already knows this..
Maybe a letter drop?
Dont click here
How do I get that T-shirt? Gawd Damn, that is a classic.
COVID bumper sticker suggestions (or suggestions for Mary’s book title)
• COVOODOO
• Trust the Seance
• You Can’t Buy Your Soul Back (I think Dr David Martin used that)
• Discovering Absurdistan (already taken by Germar Rudolf)
• The Trouble With People (already taken by William Luther Pierce)
maybe there is some hope after all…
This letter, dated July 7 2021, is addressed to the New South Wales Health Minister and Premier, and was copied to the Federal Health Minister and other Parliamentarians. It lays out the basis for concerns that “Government Agents are acting outside their powers and in a manner that may imperil the lives of patients” with respect to COVID-19.
Legal Letter Sent to State and Federal Ministers in Australia, Calling for Urgent Public Consultation and Overhaul of COVID-19 Policies
that link and other interesting links – I found on this page,
https://bsnews.info/nhs-staff-march-with-100000-in-london-for-truth-and-freedom/
included on that site is a letter from an Irish hokey player who quit rather than be forced to take the jab.
Very thorough legal letter, from page 7 to 16 the TGA gets 39 mentions, basically they took Pfizzrs word for it. They didn’t bother to do their job and test anything. They went with the promotional material. If you study John Skerritt’s resume you will see he is well suited to the various commercial aspects which “may” impinge on this position.
More Masks Than Jellyfish’: Coronavirus Waste Ends Up In Ocean. (The Guardian) Kevin Woodman.
as do the ‘surgical’ gloves 🙁
Yes… yes… I’m horrified. Terror-stricken
Now can we do something about it? LIke fighting back. We do not have to cringe, waiting for the executioner’s needle.
Anybody with family in the armed forces, by hook or by crook, show them the evidence. Because if we do not win over the army, they will track us down and hold us down for the jab.
Distribute anonymous information about the now-eventuated herd immunity; which makes testing, lockdown and vaxxing unnecessary.
Write NO TO DEATH JABS on walls.
And whatever other ideas you can think of.
But don’t admit what you are doing here or you will be in prison being jabbed anyway.
“now-eventuated herd immunity” – The herd immunity can only eventuate by people actually getting the virus. It cannot eventuate by getting ‘vaxxed’. The jab does not protect someone from getting the virus nor does it prevent the spread of the virus. I don’t think the majority of the population knows that. I keep hearing people say they have or are getting the vaccine to promote ‘herd immunity’. That is total bullshit.
I seem to recall “herd immunity” was a concept being put about &/or “re-purposed” a few years before the plandemic was initiated. Amazing how long the preparations took, I guess plandemic was next off the line after the “Patriot Act” and a few things of that nature.
Such dedication to a cause, but our leadership cabals have done all this many, many times in the past.
before and after the WHO changed things ( hope this works )
hmmmm
https://ibb.co/P4KZmSM
That would be our friend Tedros’s update, probably not the first update or the last
My normal comment got blocked, just mentioned the word “T3DR05”
Weird
Fair, I hadn’t looked to see the NEW definition of ‘herd immunity’, what a load of bullshit. The BS just keeps getting deeper and deeper, I wonder what else the Kabal will twist upside down to explain their lies.
I have to admit it, I’m having a chuckle at the absurdities that the liars keep coming up with. It is like living in a ‘Babylonian Bee’ article in real time. Freaking hilarious if you have your head screwed on tight.
how right you are Mr Shulze. day after day actually, hour by hour, its non stop – we are spoon fed demonstrable lies, dressed as information and updates, enabled by the sycophantic msm so called journalists.. ( who by the way are not only harming all of us with their aiding and abbetting of such lies – but their own families, their loved ones, and themselves! ) – what possible reward could be enough for them to sell their souls like that? – absurd indeed.
you forced me to google ‘Babylonian Bee’ – thanks for that, perfect surreality!
that Tshirt was a one off hehe! but in all seriousness, I think gumshoe should open a swagshop where people can purchase T-Shirts, coffee mugs, mouse pads … all work done ny 3rd party for example – turn absurdity into pfofit! 🙂
I’ll start with just one of those ‘I see dense people’ T-shirts. When I go into town, I’d love to see the look on people’s faces as they read it. – Duh, I don’t understand that…
Went to suburban shopping centre, bar a bakery and coffee shop everything closed, went downstairs to Coles Aldi and Liqourland bumper to bumper trolley style. Everyone looking at me as maskless terrorist endangering the herd. “Strange days indeed”, getting stranger.
Can’t wait until the c–ts show up here – https://www.bitchute.com/video/YPE0KNRMOYTC/
56…..Go to Bunnings, they will give you a free Mask Exemption Badge to wear.
Works wonders.
Moderna Representative ADMITS Vaccine is Experimental and Everyone Taking it is Part of a Clinical Trial with Unknown Consequences
By Arsenio Toledo
This admission was recorded during the June 22, 2021 episode of The Stew Peters Show by the independent conservative reporter and political commentator Stew Peters. During that day’s episode, Peters played an audio recording made by a woman who developed Guillain-Barre syndrome after receiving the Moderna vaccine. Guillain-Barre syndrome is an autoimmune disorder. It causes the body’s immune system to attack its own nerves. Its first symptoms include weakness and a tingling sensation in the extremities. This then rapidly spreads and eventually leads to whole-body paralysis. The woman’s doctor believes she got Guillain-Barre from the coronavirus vaccine. The woman’s physician, a neurologist, filed an adverse event report with the Vaccine Adverse Events Reporting System. But the woman decided this was not enough and wanted to take it up with Moderna. She called the company and spoke with a representative who was not surprised to hear about her injury. During the call, the Moderna representative read her a disclaimer:
“The Moderna COVID-19 vaccine has not been approved or licensed by the Food and Drug Administration, but it has been authorized for emergency use by the FDA under an emergency use authorization to prevent coronavirus disease 2019, for use in individuals 18 years of age and older.” “There is no FDA-approved vaccine to prevent COVID-19. The EUA for the Moderna COVID-19 vaccine is in effect for the duration of the COVID-19 EUA declaration, justifying emergency use of the product unless that declaration is terminated or the authorization is revoked sooner.”
In addition to this admission that the vaccines are experimental, the Moderna representative pointed out that all of its clinical trial phases are still ongoing and that the company still does not know the vaccine’s long-term protective efficacy. When the woman asked the representative if everybody who gets Moderna’s vaccine is a part of the company’s clinical trial, the spokesperson replied, “pretty much, yeah.” This means that millions of people all over the world are guinea pigs in a clinical trial that they have not specifically signed up to participate in.
Read the post
http://www.renegadetribune.com/moderna-representative-admits-vaccine-is-experimental-and-everyone-taking-it-is-part-of-a-clinical-trial-with-unknown-consequences/
https://i0.wp.com/www.thelibertybeacon.com/wp-content/uploads/2021/07/quiz.jpg?fit=620%2C280&ssl=1
https://i2.wp.com/ukreloaded.com/wp-content/uploads/2021/07/QUIZ-1-B-216×300.jpg?resize=455%2C630&ssl=1
https://i1.wp.com/ukreloaded.com/wp-content/uploads/2021/07/QUIZ-2-B-217×300.jpg?resize=473%2C654&ssl=1
https://www.thelibertybeacon.com/do-the-covadoodlebug-vaxadiddle-quiz/
Is All Hope Lost for Those Who Still Believe in Trump?
https://healthimpactnews.com/wp-content/uploads/sites/2/2021/01/Trump-Epstein.jpg
Donald Trump and his then-girlfriend, Melania, with the financier Jeffrey Epstein and the British socialite Ghislaine Maxwell at Trump’s Mar-a-Lago club in Palm Beach, Florida, on February 12, 2000.
https://healthimpactnews.com/2021/is-all-hope-lost-for-those-who-still-believe-in-trump/
OFF TOPIC but current:
I heard this morning that Toyota had withdrawn its advertising sponsorship from the Tokyo Olympics on the grounds that “there are many issues with these Games” and being linked with these “pandemic-era Games” would be “brand damaging”.
How’s that for chutzpah …
https://themanufacturer-cdn-1.s3.eu-west-2.amazonaws.com/wp-content/uploads/2015/10/14114554/Toyota-vehicles-feature-prominantly-in-ISIS-propaganda.-e1444420627612.jpg
https://blogs.letemps.ch/mohammad-mahmoud-ould-mohamedou/wp-content/uploads/sites/37/2015/09/1137.jpg
… How about this for “brand decimating/eviscerating”
https://www.youtube.com/watch?v=X7LerTUhxxI
Oh What a Farce! – Toyota Corona!!
I remember that video. There was a Special Forces bloke on our forum that laughed about the Toyotas. The Toyotas were all set up just like the Special Forces Toyotas, including floor boards, .50 cal gun mounts, the whole nine yards – they were a special vehicle designed for the Special Forces. The Apache helicopter was the cherry on top… – Oh yeah, this was a bunch of ragged freedom fighters out in the desert – LOL!
ISIS™ DRIVES TEXAS-MADE TOYOTA TRUCKS APPARENTLY MODIFIED FOR U.S. SPECIAL FORCES
Isn’t it strange that “ISIS” just happens to be pictured along with a convoy of Toyota trucks that at least appear to be modified the exact same way special forces has them outfitted before shipping them from the factory in Texas?
http://whale.to/c/isis_drives.html
• The Mystery of ISIS’ Toyota Army Solved – Tony Cartalucci (New Eastern Outlook)
https://journal-neo.org/2015/10/09/the-mystery-of-isis-toyota-army-solved/
• The Pentagon Threatening to Revive ISIS (Syria News September 2019)
https://syrianews.cc/the-pentagon-threatening-to-revive-isis/
(Great video featuring the voice of John Kerry just a few scrolls down)
2: ISIS Foreknowledge via Leaked DIA Doc
The DIA (Defense Intelligence Agency) is 1 of 16 US military intelligence agencies. According to a leaked document obtained by Judicial Watch, the DIA wrote on August 12, 2012 that:
“there is the possibility of establishing a declared or undeclared Salafist Principality in eastern Syria (Hasaka and Der Zor), and this is exactly what the supporting powers to the opposition want, in order to isolate the Syrian regime …”
This was written before ISIS came on to the world stage. Clearly ISIS was no random uprising, but rather a carefully groomed and orchestrated controlled opposition group.
The “supporting powers to the opposition” referred to are Saudi Arabia, Turkey and the GCC nations such as Qatar, who are in turn being supported by the US-UK-Israeli axis in their struggle to overthrow Syrian President Bashar Al-Assad. As I outlined in this article Syrian Ground War About to Begin? WW3 Inches Closer, the US is backing the Sunni nations while Russia, China and Iran are backing the Shia nations, so there is the definite potential for this to erupt into World War 3. Below are screenshots of the actual DIA document:
http://thelastgreatstand.com/wp-content/uploads/2016/06/ISIS-US-Israeli-creation-1-
• China – Syria economic agreements high on FM Wang Yi’s agenda in Syria
https://www.youtube.com/watch?v=OU9_9r-soL8
• Wang Yi: China opposes any attempt to seek regime change in Syria
https://news.cgtn.com/news/2021-07-18/Wang-Yi-China-opposes-any-attempt-to-seek-regime-change-in-Syria-11Zm0TLyxz2/index.html
Thanks JS. It led me to another interesting article –
1 Timothy 6:10 “For the love of money is a root of all kinds of evil……………..”. If that’s the case then Jews must be the main root because their Banks own most of it.
Reality Check: Costs of America’s Longest War
………And all this is happening at what cost? More than 22,000 U.S. forces have been killed or injured. But it’s the Afghans who paid the heaviest price. Brown University’s research put the casualty of Afghan national military and police at 64,000. And according to the United Nations, 111,000 Afghan civilians have been killed or injured. This is outrageous. And the economic costs are staggering too. The Pentagon’s 2020 report said the war has cost 815.7 billion U.S. dollars. But the Costs of War project put the final figure at 2.2 trillion U.S. dollars. …………
……………. But another factor—an open secret—is that war is good business. The Pentagon, the military contractors, the weapons manufacturers, the neoconservative strategists, which are all part of America’s military-industrial complex, perhaps know a thing or two about that………….
https://news.cgtn.com/news/2021-07-19/Reality-Check-Costs-of-America-s-Longest-War-121EIltvDxK/index.html
A Family Business of Perpetual War
Jews, Victoria Nuland and Robert Kagan have a great mom-and-pop business going. From the State Department, she generates wars and from op-ed pages he demands Congress buy more weapons. There’s a pay-off, too, as grateful military contractors kick in money to think tanks where other Kagans work, writes Robert Parry………….
https://consortiumnews.com/2015/03/20/a-family-business-of-perpetual-war/
…….“War is hugely profitable. It creates so much money because it’s so easy to spend money very fast. There are huge fortunes to be made. So, there is always an encouragement to promote war and keep it going, to make sure that we identify people who are ‘others’ whom we can legitimately make war upon.” Roger Waters, Co-founder of the rock band Pink Floyd.
.
Read on –
.
https://www.globalresearch.ca/the-united-states-of-america-the-real-reason-why-they-are-never-winning-their-wars/5654433
https://upload.wikimedia.org/wikipedia/commons/d/d6/The_cow_pock.jpg
Thanks to everyone in this brilliant column. So who needs a minotaur?
Here is more of the Russian story. Wow.
https://www.ucis.pitt.edu/nceeer/1984-626-3-2-Rapoport.pdf
Thank you Mary – for that great find you get to watch a movie …
(Others might not know that) Joseph E Davies was the US Ambassador to the Soviet Union from 1936 to 1938 – the height of The Terror – and was very fond of Uncle Joe. Not only did he consider the Show Trials credible and the convictions and sentences fair, he turned his back on American ex-patriots wallowing and dying in the Gulag death camps as they were not worth rocking the diplomatic boat over (I’ve said too much already).
Anyway, without further ado, here is Davies presenting the movie to His Friend Joe …
“To one of the very great men of this ear of history – Joseph V. Stalin, Premier of the Government of his People … Whose vision, Power and Greatness enabled his people to save themselves and their land from enslavement by the Hun. And but for whose Valiant and Immortal Defense of the Ramparts of Liberty and Freedom, that Civilisation which Free Men must have to live, would have been utterly destroyed. With the great respect and sincere admiration of His Friend””
Source [18]: May 20,1944, Joseph Davies diary, Joseph Davies Papers, Library of Congress Manuscripts, Washington D.C.
• Mission to Moscow – Joseph E Davies
https://www.bitchute.com/video/7SMVfca4HhlD/
Young Fish, I was a bit worried tht it said “DIA” which i take to mean Defense Intelligence Analysis, but prior to 1947 (what a wonderful year) we had a War Dept, not a Defense Dept, so maybe the letters DIA stand for something else.
Thanks for your many contributions. I want to suggest this one to you but cannot stor to discuss it — Owen Lattinore’s “Inner Asian Frontiers of China” (1940). Knockout.
Wikipedia’s list of american ambasadors to Russia, starting in 1789, has some interesting names:
https://en.wikipedia.org/wiki/List_of_ambassadors_of_the_United_States_to_Russia
Diane, at the top of this column you posted re Walt Disney. What are we supposed to do with it?
https://exposingpedovore.wordpress.com/2019/12/11/mk-ultra-mindcontrol-levels-of-programming/
Dear Dinkum, I’m sorry for your troubles, but think of it this way — at least you don’t have to carry a tuba:
https://www.youtube.com/watch?v=IC1SKsFePLo
thanks for your thoughtfulness Mary, and also for the OOmPah!
I grew up on that crap! 🙂
despite any implied troubles, Im not going too bad here and I do appreciate all the little things in life.. thats all I have,
Im thankfull for a few old comrades, and the fact that I dont need carry a tuba, but even even if i could carry a tuba, begging indulgence, I gotta ask…
would a *didgeridoo?
https://www.youtube.com/watch?v=cizByru14jc
*with a touch of STOMP
Much better !
”this is injecting a stimulant to produce a toxin for the secondary benefit […] of building an immune response to the toxin your body is producing.”
<b”>You’re not getting a pathogen that your body is responding to with an immune response, [LISTEN UP] you’re getting the instructions for your cells to create the pathogen and then you hope[!] that your body, in response to the pathogen you were told to create – you hope your body comes up with an immune response.” [See the full interview and statement in the following]
• STEW PETERS: INTERVIEW WITH DR. DAVID MARTIN – ‘PATENTED GENOCIDE’
https://www.bitchute.com/video/6MS6wiOFb3dI/
I still can’t connect all the dots re “China” [seems to slip in and out of context], but for 2 minutes, 45 seconds from 31:00, Dr David Martin states the following:
“What has been done is we’ve chosen the cunning use of the term “vaccine” despite the fact that “vaccine” as a defined term – even the Patent Office had to school Anthony Fauci […] on what a vaccine is because Anthony Fauci was in fact trying to get a vaccine that wasn’t one – and fact checkers hate when I say this, but there is in fact a legal standard for what a vaccine is and there is also an FDA standard for what a vaccine is and this is neither.
The fact of the matter is in the case of the Moderna and the Pfizer shot this is injecting a stimulant to produce a toxin for the secondary benefit – you hope! – of building an immune response to the toxin your body is producing.
But listen to what I just said because it is technically unfortunately correct.
You’re not getting a pathogen that your body is responding to with an immune response, [LISTEN UP] you’re getting the instructions for your cells to create the pathogen and then you hope[!] that your body in response to the pathogen you were told to create, you hope your body comes up with an immune response.
But here is the tiny problem. The clinical trials did not measure immune response – they did not measure infection response – and they did not measure your transmission response. So every public health benefit that vaccines purport to have was never measured in these trials.” [End quote]
Let me repeat that one phrase:
“this is injecting a stimulant to produce a toxin for the secondary benefit […] of building an immune response to the toxin your body is producing.
In my own words – as Dr Martin states emphatically elsewhere (as do Aussiemal and Cherri et al repeatedly) – THERE IS NO VIRUS – they are injecting the toxin in order to trick the body into building an immune response to something that was never there … aka we are being experimented on to perfect a means of biochemical genocide for around Seven Billion people.
Earlier, Michael made reference to “the most dangerous drug known to mankind – ambition”. Our politicians and so-called “Health Experts” all know this – these ambitious collaborators have been promised a place in the Survivors’ Club … they are the true “enemies of the people” and should be dealt with as such. They should research how it turned out for the likes of the genocidal psychopaths Yagoda, Beria and Trotsky et al after they had outlived their usefulness – or Andronicus I of Constantinople for that matter.
https://www.youtube.com/watch?v=PDd8shcLvHI
vaccine (n.)
“matter used in vaccination,” 1846, from French vaccin, noun use of adjective, from Latin vaccina, fem. of vaccinus “pertaining to a cow” (see vaccination). Related: Vaccinal; vaccinic.
https://www.etymonline.com/search?q=vaccine
Great interview. Two very focused, intelligent individuals hammer out a no bullshit interview. Should be required viewing by all.
I cant believe im posting this.
https://www.youtube.com/watch?v=5DkWcbPPw18
https://www.youtube.com/watch?v=euMuCRx7qhA
What a hoot of a Herald-Sun picture !
They all look like ABC Play-skool comperes
https://www.youtube.com/watch?v=c_tcg9kOfkg
1,069 Bitcoin Mining Rigs Destroyed By Malaysian Police With A Steamroller
July 20, 2021
Malaysian cops seized and destroyed 1,069 bitcoin mining rigs by crushing them with a steamroller — after the miners allegedly siphoned off almost $2 million worth of electricity to power the energy-intensive machines.
https://greatgameindia.com/bitcoin-mining-rigs-destroyed/
These people put the West in general to shame –
https://www.youtube.com/hashtag/gloriousthingsoftheearespoken
OneWeb will render us all, rats in their cages, stupified beyond redemption. In a trance, illuminated by screens, we are fooled into the BS (beast system).
Descendants of liars, since the beginning, now enforcing the illumination of their artificial insanity
with lethal injection mandates on all living.
There is only Love and there is evol pushed.
No words of kindness from the taken, directing this scam hellbent, just look at the masonic tools and witness their vacant eyes possessed. Don’t comply, if you can.
Everyone knows the politicians are paid actors, professional liars, and now they are being asked to stretch reality into a shape nobody has ever seen before, but that is their commission and they will fulfil it in the usual way, with a stream of barefaced lies. What are they concealing ? What is the 2nd and 3rd agenda ? Everyone is being brought home and travel is banned. The trade wars against China are escalating. Who will be the proxies for the US and China, if China can even get a proxy, North Korea was already “disabled” politically ($$$ ?). Now we see the Philippines has backflipped; before, Duterte was saying “It will be a massacre”, now he is pushing back. Are we building a coalition to enforce the Hague ruling that the reefs belong to the Philippines ? Is that why Russia is arming up so blatantly, with the world’s biggest submarine and the world’s fastest ICBMs ? Russia might like to stay independent as the entire Chinese military infrastructure is subjugated.
Remember Taiwan has 90% of the world chips, this is a better guarantee than any treaty. It seems the CCP has really lost the plot. Maybe they should get out more. Yuan hegemony might not be bought as cheaply as they would have hoped.
https://www.bangkokpost.com/world/2151295/philippines-challenges-chinese-warship-in-s-china-sea
China becoming aggressive in LCD panel, microchip production
KOTARO HOSOKAWA, Nikkei staff writerNovember 12, 2015 12:00 JST
TOKYO — China is expanding its presence in the field of key components for the electronics industry, such as liquid crystal display panels and semiconductors. In China, seven state-of-the-art LCD panel factories will come onstream over the next three years, and there has emerged a plan to construct one of the world’s largest memory chip plants.
These are among the 9,000 workers who churn out high-resolution LCD panels for smartphones at Tianma’s Xiamen plant.
Backed by the Chinese government's funding power, the country seems to be trying to control the global digital industry through aggressive, massive investment despite the risk of excess facilities.Tianma Microelectronics, a Chinese maker of small and midsize LCD panels, has a factory in Xiamen, a city in China's southeast province of Fujian, which faces Taiwan across the Taiwan Strait. The factory is located in an industrial park a half hour's drive east of the city center. Its 600,000-sq.-meter site, an area equivalent to 85 soccer grounds, which was provided by the local government, includes a number of 17-story condominiums for employees and is surrounded by many stores. In just two years since the plant went onstream, a town has grown around it..................
https://asia.nikkei.com/Business/China-becoming-aggressive-in-LCD-panel-microchip-production
We’ve seen pictures of the large internment camps in the UK. It looks like something similar is being planned in the US. Here’s a recent document –
https://www.americanpartisan.org/2021/07/ussa-news-dhs-training-course-prepare-for-mass-public-quarantine-of-unvaccinated-rural-americans
Maybe in Australia they just decided to use Sydney and Melbourne…
A fine thing is a wood shaving, from a hand plane
no.5, you can see through. Miss that world dearly, the sooner we get back, to it the better. Wood 🪵 workers know the feeling that is artifice brutality and innocence.